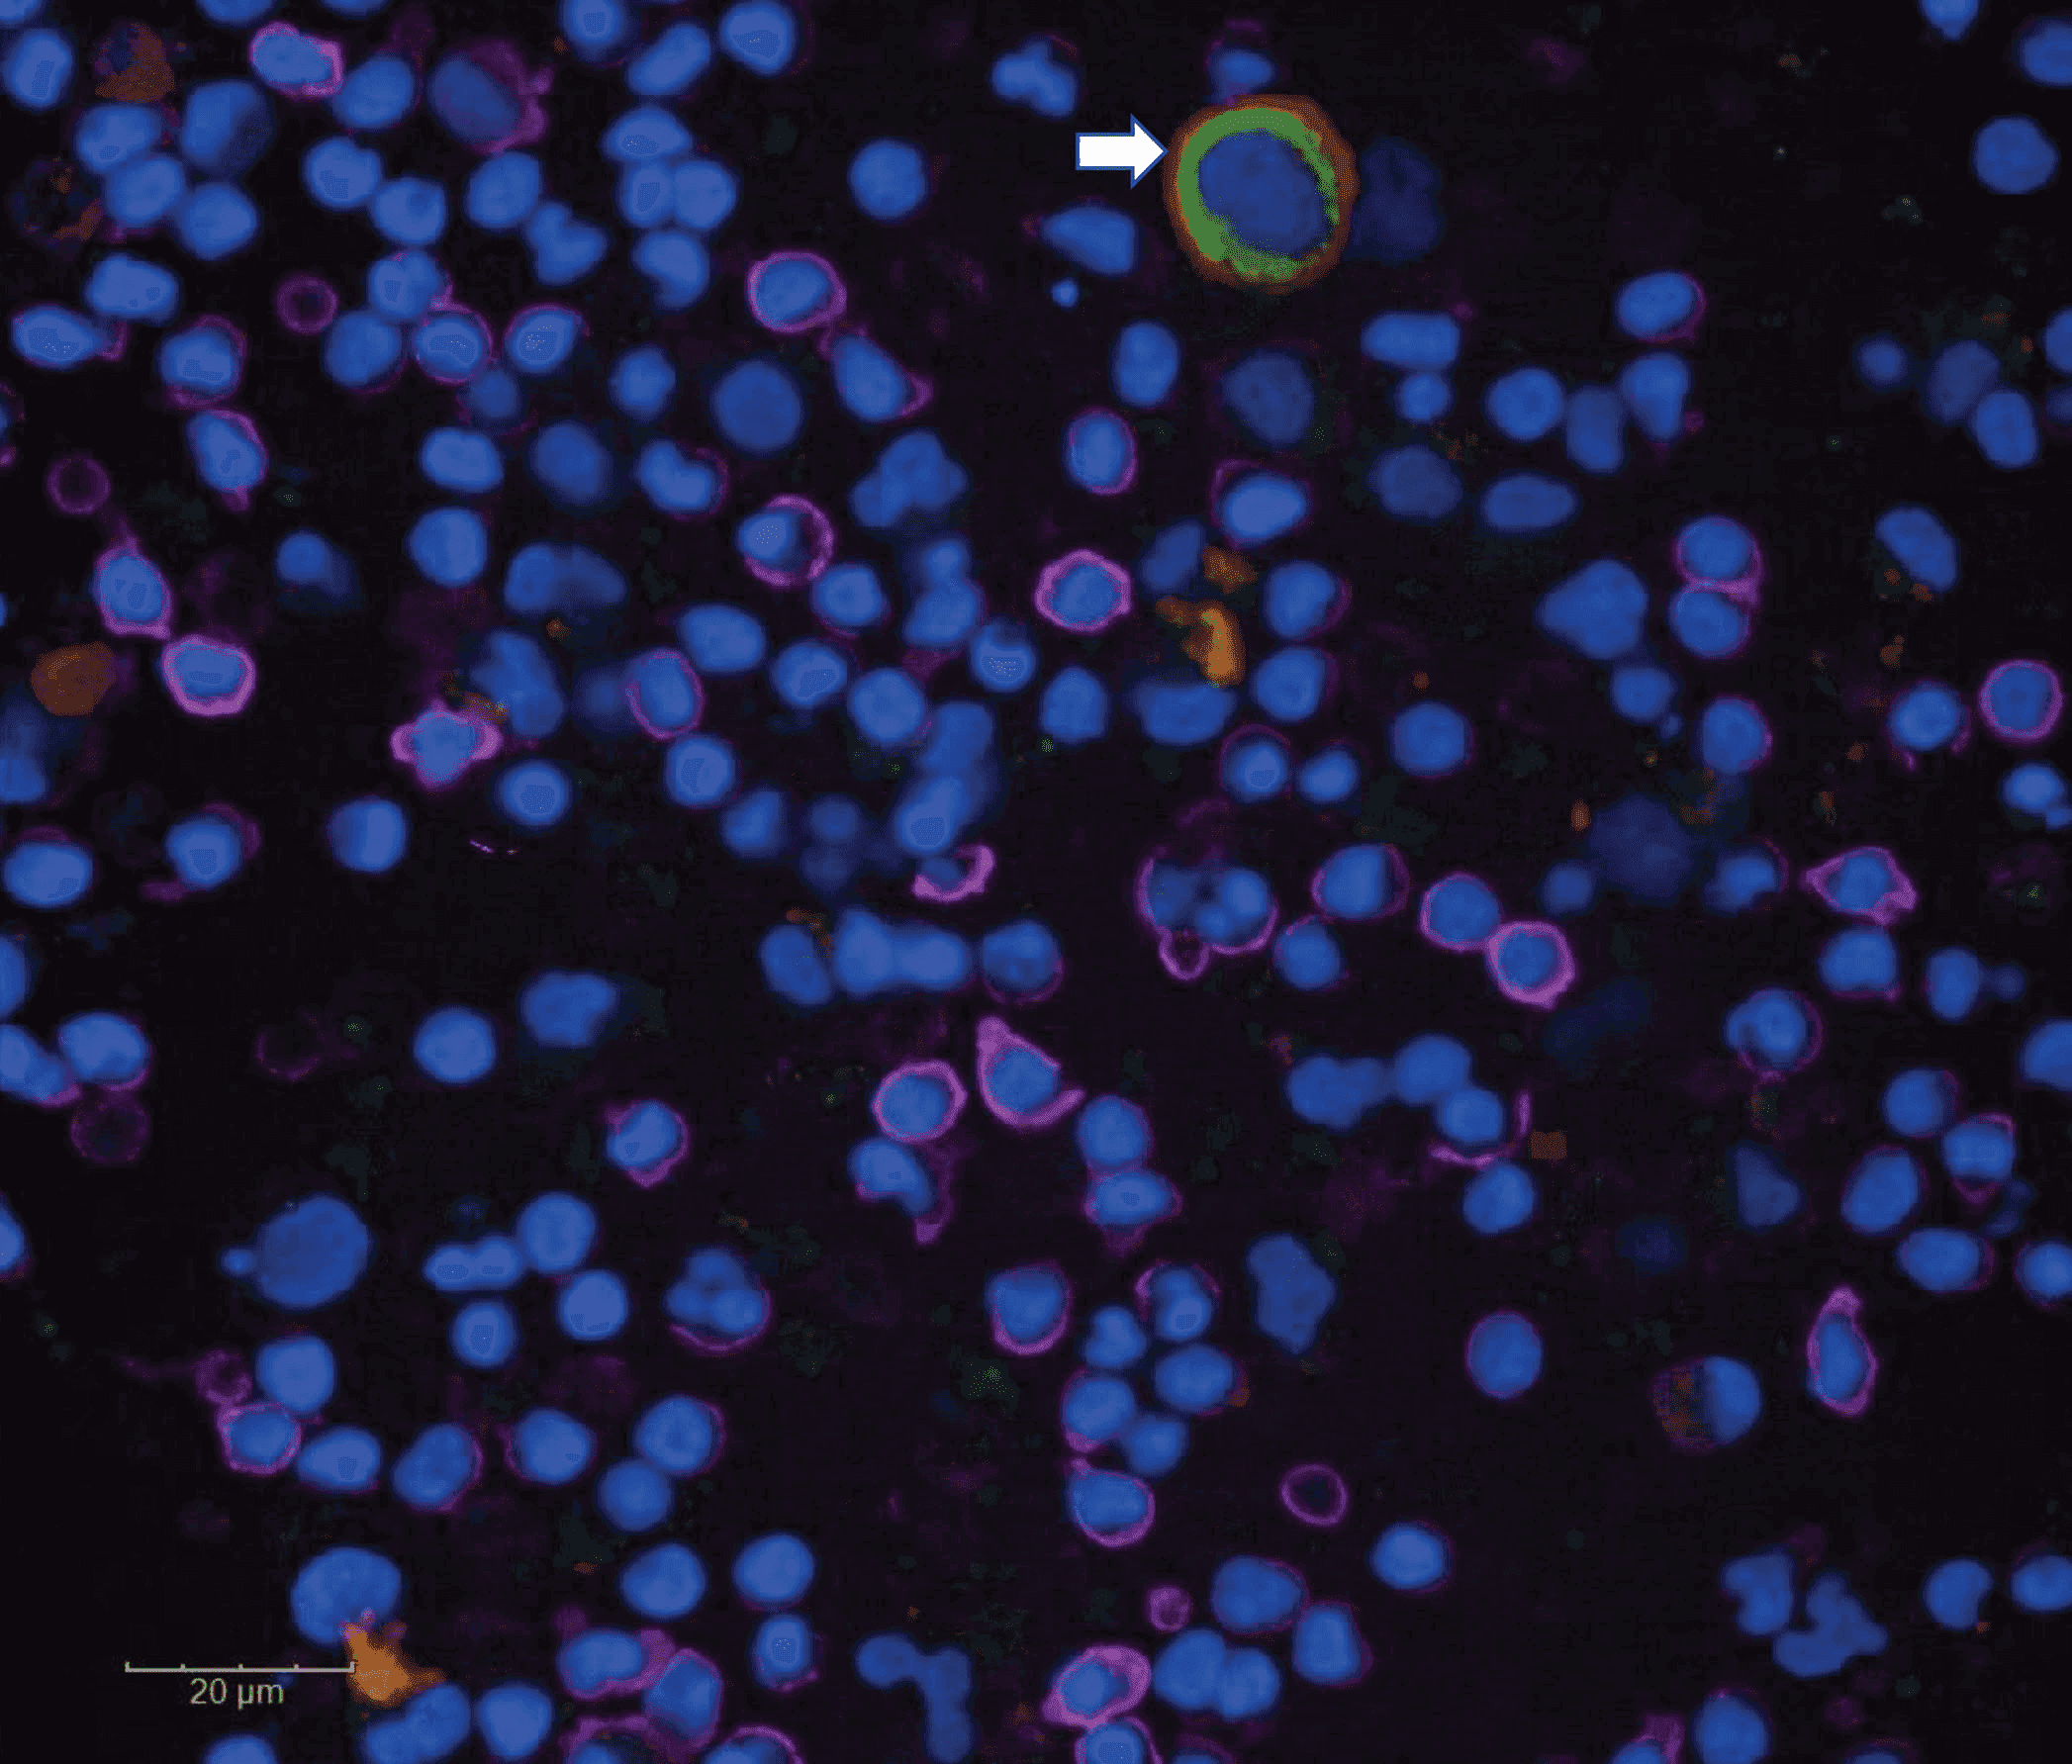

TruCheck™ Early Cancer Screening Blood Test
The TruCheck™ Early Cancer Screening blood test is a thorough check for the existence of cancer in your body, identifying which type of cancer(s) you have, and from which organ they have originated.
About Test
The TruCheck™ Intelli Early Multi-Cancer Screening blood test checks your blood sample for Circulating Tumour Cells (CTCs), and clusters of the cells. New in the UK, this test is revolutionising the ability to detect cancer at its earliest stages, and we are proud to be one of the first providers in the country to offer it to the British public. A non-invasive procedure, this test requires a simple blood test appointment to draw a small sample from a vein in your arm. This sample is then analysed at a leading UK laboratory to detect the existence of any CTCs and therefore to determine whether you have any cancers currently in your body.
Test Providing Labs
Early cancer detection improves outcomes — tested in Switzerland and the UK.


More details
Trucheck Non-Invasive, Blood-Based Multi Cancer Screening
The TruCheck™ Early Cancer Screening blood test is a thorough check for the existence of cancer in your body, identifying which type of cancer(s) you have, and from which organ they have originated.
Trucheck test is a paradigm shift in cancer screening as it is non-invasive and does not involve radiation. It can be availed through a simple blood draw, maybe even from the comfort of your home! It can help avoid procedures which maybe retrospectively found to be unnecessary. The test is performed at our state-of-the-art laboratory meeting the international quality standards.

Trucheck - Intelli
Trucheck Intelli cancer test covers screening for over 70 solid organ cancers. These include Lung, Breast, Prostate, Gastrointestinal, Head and neck, Gynecological, Urinary and biliary tract, CNS cancers, Melanoma, Mesothelioma etc. TM Certain sub-types of cancers are not covered in Trucheck -Intelli.
Advantages
Peace of Mind
Cancer screening test for peace of mind!
70 Solid Organ Cancers
Cost effective, provides screening for 70 solid organ cancers
Non-Invasive
Non-invasive and can be done without visiting a hospital or a screening centre.
No Wait Times
No wait times for appointments
Avoid Unnecessary Procedures
Helps avoid procedures that may be retrospectively found unnecessary
No Risks
No risks associated with invasive procedures.
Which cancers does the test check for?
Trucheck Intelli cancer test covers screening for over 70 solid organ cancers. These include Lung, Breast, Prostate, Gastrointestinal, Head and neck, Gynecological, Urinary and biliary tract, CNS cancers, Melanoma, Mesothelioma etc. TM Certain sub-types of cancers are not covered in Trucheck -Intelli.
How It Works
From collection to results, our simple process ensures accuracy, privacy, and world-class precision every step of the way.
Blood Sampling
We obtain your blood samples via accredited laboratories.
Shipping to UK for analysis
The blood samples were sent for testing to ensure premium and accurate results.
Processing and reporting
Our experts will share the results with you and provide guidance.
Result Delivery
Our experts will share the results with you and provide guidance.
Personalised program
Our experts will share the results with you and provide guidance.
Why is this test so revolutionary?
Launched in the UK in late 2022 after rigorous clinical trials, this test is brand new to the diagnostic screening industry. It is the only test available publicly to check for Circulating Tumour Cells (CTCs), detecting even the tiniest existence of cancer from a small blood sample. Highly accurate, it not only identifies whether you have CTCs, but also where they originated. This means you know where in your body the primary tumour is located, speeding up diagnosis and treatment, and enabling doctors to focus treatment on the required areas.


Frequently asked Questions
From collection to results, our simple process ensures accuracy, privacy, and world-class precision every step of the way.
Trucheck is a revolutionary blood test that screens for over 70 types of solid organ cancers. It is non-invasive, radiation-free, and requires only a simple blood draw.